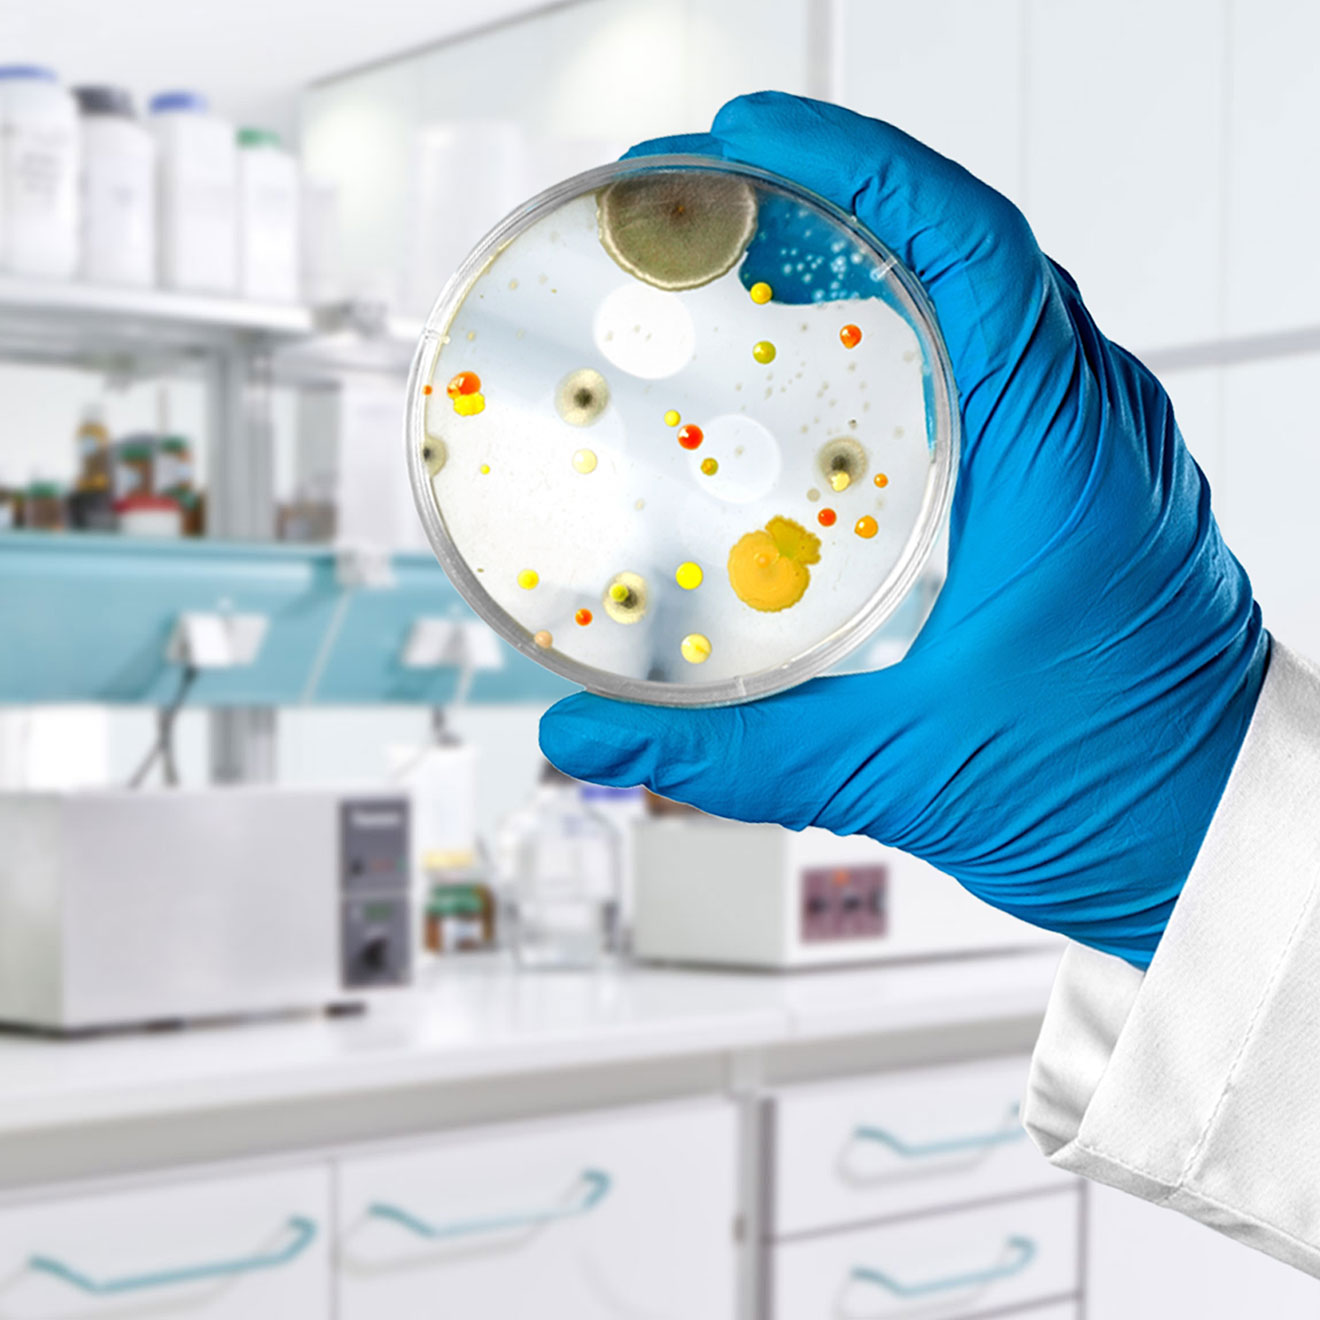

Wir analysieren Trinkwasser und prüfen Trinkwasseranlagen
Als verlässlicher Partner setzt das Wasserlabor seine spezifischen Kenntnisse gerne ein. Lesen Sie mehr über Service und Leistungsspektrum.

Leistungsspektrum

Über unser Wasserlabor
Das Wasserlabor ist Ihr Partner für alle Fragen und Dienstleistungen rund um die Wasseranalytik. Daneben bietet es Lösungen für die Analyse unterschiedlichster Medien an (Aktivkohle, Öle, Gase etc.).
Unser Wasserlabor verfügt über jahrzehntelange Erfahrung im Umgang mit dem Trinkwasser in Köln und Umgebung. Keiner kennt die Charakteristika der Oberflächen-, Grund- und Trinkwässer in unserer Region besser.
Sein umfassendes Qualitätsmanagementsystem wurde von der Deutschen Akkreditierungsstelle GmbH (DAkkS) auf Basis der DIN EN ISO/IEC 17025 akkreditiert.
Als verlässlicher Partner für Installateure, Ingenieurbüros, Industrie- und Gewerbebetriebe, Badesee- und Schwimmbadbetreiber, Kommunen, Gesundheitsbehörden und andere Wasserversorgungsunternehmen setzt das Wasserlabor seine spezifischen Kenntnisse gerne ein.
Bei den bakteriologischen und chemischen Untersuchungen stellen unsere Fachleute durchdachte Analysenkonzepte und moderne, hochempfindliche Analysetechniken mit hohem Automatisierungsgrad eine zuverlässige und schnelle Bearbeitung sicher.
Ihre Vorteile im Überblick
-
passgenauer Komplett-Service: Planung der Untersuchungen, Probennahme, Analytik und Bewertung der Untersuchungsergebnisse
-
spezifisches Praxiswissen
-
moderne Analysetechniken
-
schnelle und sichere Bearbeitung
Informationen zur Akkreditierung
Akkreditierungsurkunde für das Wasserlabor der RheinEnergie
Von der DAkkS ausgestellte Bescheinigung unserer Akkreditierung nach DIN EN ISO 17025 (1.3 MB)
Anlage zur Akkreditierungsurkunde, Teil 1
Übersicht der im Labor vorhandenen akkreditierten Prüfverfahren (354 KB)
Anlage zur Akkreditierungsurkunde, Teil 2
Übersicht der im Labor vorhandenen akkreditierten Prüfverfahren (230 KB)
Liste der Prüfverfahren im flexiblen Geltungsbereich der Akkreditierung
Weitere im Labor vorhandene akkreditierte Prüfverfahren (246 KB)
Legionellen-Check
Anerkannte Legionellen-Prüfung durch unser Wasserlabor
Wir versorgen Sie vom Wasserwerk bis zu Ihrem Hausanschluss mit qualitativ hochwertigem Trinkwasser. Für den einwandfreien Zustand der Trinkwasserleitungen sind Sie als Immobilienbesitzer verantwortlich. Zur Einhaltung von gesetzlichen Vorschriften oder einfach um sicherzugehen, können Sie bei uns einen Legionellen-Test beauftragen.
Das Trinkwasser aus Ihrer Leitung wird in unserem Wasserlabor genau untersucht. Die Überprüfung reicht von der korrekten Beprobung bis hin zur exakten Analyse. Neben Bakterien- und Schwermetall-Tests bieten wir Ihnen u. a. auch eine sichere, unabhängige und anerkannte Legionellen-Prüfung an.
Unsere Leistungen umfassen die Vorabüberprüfung der Untersuchungspflicht auf Legionellen, eine fachgerechte Probeentnahme und die unabhängige und anerkannte Legionellenprüfung durch unser Wasserlabor. Bei Legionellenfund erhalten Sie einen Prüfbericht mit Handlungsempfehlung.
Ihre Vorteile im Überblick
-
Einhalten Ihrer Pflichten als Immobilienbesitzer
-
Sicherheit bei der Einhaltung der TrinkwV
-
rechtzeitiges Aufzeigen von ungenügender, veränderter Wasserqualität
-
Ergebnisbericht und Beratung hinsichtlich der Mängelbeseitigung
-
unkomplizierter und fachgerechter Service aus einer Hand
Kontakt

Sie haben Fragen zu unseren Wasserdienstleistungen?
Wir kümmern uns um Ihr Anliegen! Wir freuen uns auch über Feedback zu unseren Dienstleistungen und Anregungen – denn Ihre Zufriedenheit liegt uns am Herzen. Sie erreichen uns unter:
Mo-Fr: 7:30 bis 17:00 Uhr
Wie das Beschwerdemanagement beim Wasserlabor abläuft, erfahren Sie in unserer Prozessdarstellung:
pdf | 388 KB